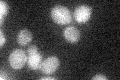
YPR093C
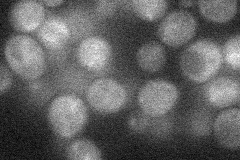
YPR093C

View description
Ubiquitin ligase that modifies and regulates RNA Pol II; involved in a putative alcohol-responsive signaling pathway; accumulates in the nucleus under alcohol stress; contains a Ring/PHD finger domain similar to the mammalian rA9 protein
Localization:
Intensity:
Fold change:
Significance:
-
C’ GFP library in SD
cytosol19.32 -
N' NOP1pr-GFP in SD
cytosol19.4414 -
N' TEF2pr-mCherry in SD

below threshold4.91651 -
N' NATIVEpr-GFP in SD

below threshold18.6473 -
N' TEF2pr-VC and Cyto-VN in SD

#N/A0 -
C’ GFP library in SD+DTT

cytosol17.090.88No -
C’ GFP library in SD+H2O2

cytosol17.240.89No -
C’ GFP library in Starvation Media

cytosol14.460.74No -
C’ GFP library on the background of Pup2-DaMP

cytosol -
C’ GFP library on the background of CCT mutant

cytosol21.61541.11797No
